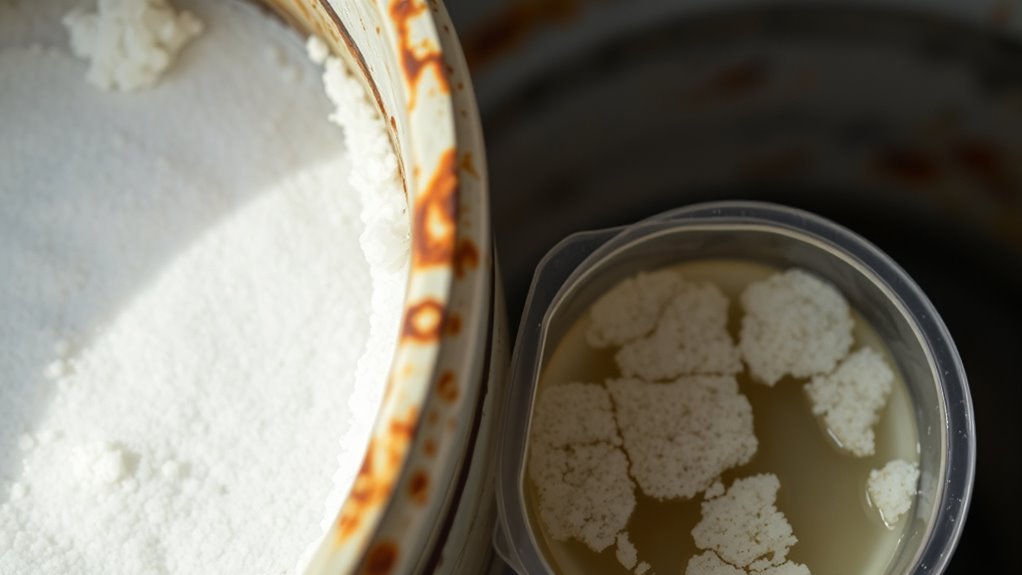

Many believe brine tank issues are rare or just need simple refilling, but proper care involves checking salt levels, preventing salt bridges, and monitoring water chemistry. Myths about ignoring minor signs can lead to bigger problems like clogging or poor softening. Maintaining the right salt type and levels, inspecting regularly, and troubleshooting odors or noises are key. Keep these facts in mind, and you’ll learn what truly matters for a well-functioning system.
Key Takeaways
- Regularly inspect for salt bridges, mushing, and residue; prevention through proper salt placement and high-quality salt is essential.
- Maintain correct salt levels; avoid overfilling or underfilling to prevent bridging, mushing, and poor regeneration.
- Clean the tank every 6-12 months to remove buildup, crusts, and bacterial growth that cause odors and system inefficiencies.
- Don’t ignore subtle signs like cloudy water, odors, or irregular regeneration cycles; they indicate underlying system issues.
- Seek professional help if problems persist after routine maintenance, especially with water quality, system errors, or persistent odors.
Common Misconceptions About Water Softener Brine Tanks

Many people believe that brine tanks require no regular maintenance or oversight, but this is a misconception. Proper care involves monitoring water temperature and pH balance to ensure the system functions correctly. If the water temperature gets too high or too low, it can affect the salt’s ability to dissolve properly, impacting regeneration cycles. Similarly, maintaining the correct pH balance prevents issues like salt bridging or clogging. You should regularly check these factors because neglecting them can lead to poor water softening performance and damage to your system. While the tank might seem straightforward, subtle changes in water chemistry and temperature can cause big problems. Staying vigilant about these elements helps keep your softener running smoothly and extends its lifespan. Additionally, understanding the importance of proper maintenance practices can prevent costly repairs and ensure consistent water quality.
The Role of Salt in Your Softening System

Salt is essential for regenerating the resin that softens your water, so maintaining the right levels is vital. Using the proper type of salt helps prevent issues and keeps your system running efficiently. Knowing how different salt types affect your softener can save you time and trouble.
Salt’s Impact on Resin
The effectiveness of your water softening system heavily depends on the quality and amount of salt used, as it directly influences the resin’s ability to remove hardness minerals. Different salt types, such as rock, solar, or evaporated salt, can affect resin performance and longevity. High-quality salt minimizes impurities that can clog or foul the resin bed, helping it last longer. Using the right salt ensures the resin regenerates properly, maintaining its capacity to soften water efficiently. Poor-quality or contaminated salt can lead to resin fouling, reducing its lifespan and increasing maintenance needs. To maximize resin longevity, choose the appropriate salt type and keep your system well-maintained, avoiding unnecessary resin replacements and keeping your softening system operating smoothly.
Proper Salt Levels
Maintaining proper salt levels in your softening system guarantees it functions efficiently and prolongs the life of the resin. When salt dissolves correctly during the regeneration cycle, it creates a brine that effectively removes mineral buildup from the resin beads. Too little salt can hinder salt dissolution, leading to incomplete regeneration and hard water issues. Conversely, excessive salt not only wastes resources but can also cause salt bridging, which prevents proper contact between salt and water. Regularly checking and maintaining the right salt level ensures consistent salt dissolution, preventing mineral buildup that can impair system performance. Staying vigilant about salt levels helps your water softener operate smoothly, reducing maintenance needs and extending its lifespan.
Common Salt Types
Choosing the right type of salt is essential for ideal softening system performance. Not all salt types work equally well, so understanding your water quality helps determine the best choice. Standard rock salt is affordable and common, but it may contain more impurities that can clog your system over time. Solar salt is purer and dissolves easily, making it a popular choice for many households. Evaporated salt offers the highest purity, reducing the risk of buildup and maintenance issues. Your water quality influences which salt type is most effective; for example, hard water with high mineral content benefits from premium options. Regularly inspecting and maintaining your salt levels can help prevent common system issues and ensure consistent performance. Selecting the appropriate salt guarantees your system operates efficiently, prolongs its lifespan, and keeps your water soft and clean.
How to Recognize When Your Brine Tank Needs Attention

If your water softener isn’t performing as well as it should, it’s a good idea to check your brine tank for signs of trouble. One red flag is chemical buildup, which can appear as crusty or sticky residue inside the tank. This buildup can hinder the regeneration process, reducing efficiency. Water discoloration, such as brown or cloudy water, may also indicate issues with salt or mineral deposits affecting the tank. Additionally, if you notice salt bridging or mushing, it’s a sign that your tank needs attention, but these are topics for later. Regularly inspecting your brine tank for these signs helps ensure your water softener functions properly and prolongs its lifespan. Addressing these issues early prevents costly repairs and maintains water quality. Proper headphone maintenance can also help prevent similar issues with your devices, ensuring longevity and optimal performance.
Debunking Myths About Salt Bridges and Mushing

Many homeowners believe that salt bridges and mushing are inevitable problems in water softeners, but these issues are often misunderstood. Salt bridges form when a hard crust of salt creates a gap between the salt and water, leading to mineral buildup and a salty taste in your water. However, proper maintenance and correct salt placement can prevent this. Mushing occurs when softener salt dissolves into a sludge, which can clog the system and cause mineral buildup. Despite common fears, these problems aren’t unavoidable if you avoid using low-quality salt or overfilling the tank. Regularly inspecting your brine tank and using the right type of salt helps prevent salt bridges and mushing, ensuring your water stays soft and free of unwanted mineral deposits. Additionally, understanding contrast ratio and its impact on water clarity can help you better evaluate and maintain your filtration system.
The Importance of Proper Salt Levels

Maintaining the correct salt level in your brine tank is essential for your water softener to function effectively. Proper salt levels ensure efficient regeneration, helping with chlorine removal and pH adjustment. When salt levels are too low, the system struggles to produce enough brine, reducing its ability to tackle contaminants. Conversely, too much salt can cause salt bridging and mushing, hindering operation. To keep things ideal, remember:
- Keep salt above the minimum fill line
- Avoid overfilling to prevent bridging
- Use the right type of salt for your system
- Regularly check salt levels monthly
- Ensure the salt dissolves properly for consistent regeneration
Proper salt levels directly impact your water’s quality and the longevity of your softener, making it a key part of effective brine tank care.
What Really Causes Hard Water Problems Despite a Softener

Even with a softener in place, hard water problems can persist when the system isn’t functioning properly or isn’t set up correctly. Poor water quality may contain high levels of minerals that overwhelm your softener’s capacity, leading to mineral buildup on fixtures and appliances. If your softener isn’t regenerating on schedule or isn’t regenerated enough, it won’t effectively remove minerals, allowing hardness to remain. Additionally, incorrect settings or installation errors can reduce efficiency, causing mineral deposits to accumulate despite having a softener. Sometimes, the source water itself is so mineral-rich that standard softening struggles to fully address the problem. Understanding these factors helps you identify whether your system needs adjustment or if your water quality requires additional treatment.
Signs Your Brine Tank Is Not Functioning Correctly
A brine tank that isn’t functioning properly can cause your water softener to underperform or fail altogether. You might notice signs like inconsistent water quality or mineral buildup. Watch for these indicators:
- Increased water mineralization, leading to scaling on fixtures
- Salt bridges or salt mushing, preventing proper regeneration
- Unusual pH imbalance, causing water to feel off or corroded
- Low salt levels that don’t seem to regenerate the resin
- Softener regeneration cycles that are irregular or incomplete
These issues typically point to problems with the brine tank’s ability to produce and deliver brine effectively. When the tank isn’t functioning properly, it can disrupt the delicate balance needed for ideal water mineralization and pH levels, impairing the softening process. Proper maintenance of the drain system and regular cleaning can help prevent some of these issues.
Maintenance Tips for a Healthy Brine Tank

Keeping your brine tank healthy starts with regular salt replenishment to guarantee proper water softening. You also want to prevent salt bridges, which can block the system, and stick to a consistent cleaning schedule. These simple steps help your system run smoothly and avoid future issues. Additionally, monitoring for system malfunctions can help detect problems early and maintain optimal performance.
Regular Salt Replenishment
Regularly replenishing the salt in your brine tank is essential for maintaining your water softener’s efficiency. Proper salt levels ensure the system can regenerate effectively, which directly impacts water quality. If salt levels drop too low, mineral buildup can occur, reducing softening performance. To keep things running smoothly, check your salt levels weekly and top off as needed. Visual cues help, like a clear salt bridge or a visible salt level below the water line. Remember, consistent salt addition prevents issues like channeling or poor regeneration. By maintaining appropriate salt levels, you support ideal water quality and prolong your system’s lifespan. Here’s what to keep in mind:
- Check salt levels regularly
- Keep salt above the water line
- Use high-quality salt
- Avoid letting salt sit too long
- Watch for salt bridges
- Monitoring salt levels is also crucial for media bed health and system longevity.
Preventing Salt Bridges
When you maintain proper salt levels in your brine tank, it’s also important to prevent the formation of salt bridges. Poor salt quality can contribute to bridging, so choose high-quality, free-flowing salt to reduce clumping. Avoid overfilling the tank, as excess salt can settle unevenly, creating bridges. Regularly inspect the salt layer and break up any formations with a broom handle or similar tool. Proper salt distribution helps preserve your resin by ensuring consistent regeneration cycles. Additionally, keeping the salt at the correct level prevents salt from compacting tightly, which can hinder water flow. Ensuring compliance with safety standards and conducting regular maintenance checks also support system longevity. By managing salt quality and preventing bridges, you support resin preservation and ensure your system functions efficiently. This proactive approach reduces issues and extends the lifespan of your water softener.
Cleaning Schedule Routine
Establishing a consistent cleaning schedule for your brine tank is essential to maintain its efficiency and prevent buildup issues. Regular maintenance helps keep water quality high and ensures your system operates smoothly. To stay on top of it, consider these routine steps:
- Check salt levels monthly to avoid low water quality.
- Clean the tank every 6-12 months to remove sludge and salt bridges.
- Rinse out residue and buildup with water and vinegar.
- Inspect for salt bridges or clogs that hinder system efficiency.
- Replace salt and filters as recommended by the manufacturer.
- Remember that dad’s wisdom about routine care and attention can make all the difference in system longevity and performance.
Troubleshooting Noise and Odors in the System

Noise and odors from your brine tank can indicate underlying issues that need prompt attention. Unusual sounds might be caused by mineral buildup, which can interfere with proper operation, creating knocking or gurgling noises. Odors often stem from airborne bacteria thriving in the moist environment, especially if the tank isn’t cleaned regularly. If you notice a foul smell, it’s a sign to check for bacterial growth and clean the tank thoroughly. Mineral deposits can also trap debris, worsening odors and causing noise. Regular maintenance, including flushing out the tank and removing buildup, helps prevent these problems. Keeping the brine tank dry and well-ventilated minimizes airborne bacteria, reducing odors and ensuring smoother system operation. Addressing these issues promptly keeps your system running efficiently. Incorporating filter replacement indicators and monitoring air quality can further help maintain optimal performance.
When to Call a Professional for Brine Tank Issues

If your brine tank shows persistent leaks, unusual noises, or foul odors, it’s a sign you might need professional help. These issues could indicate complex problems beyond simple troubleshooting. Don’t hesitate to call an expert if you notice signs of serious malfunction.
Signs of Complex Problems
Wondering when to call a professional for your brine tank? If you notice persistent issues with water quality or system efficiency, it’s time to seek expert help. Signs of complex problems include:
- Water that’s cloudy, foul-smelling, or discolored
- Reduced flow rate or pressure throughout your system
- Unusual salt buildup or corrosion around the tank
- Frequent system resets or error messages
- Inconsistent softening performance despite regular maintenance
These issues often indicate deeper tank or system malfunctions that simple troubleshooting can’t fix. Addressing them promptly prevents further damage and ensures your water remains safe and clean. Recognizing these signs helps you know when professional intervention is necessary to maintain ideal water quality and system efficiency.
When to Seek Expert Help
Recognizing when to call a professional can save you time and prevent further damage to your brine tank. If you notice persistent salt curing buildup that doesn’t resolve with basic cleaning, it’s time to seek expert help. Salt curing can cause resin degradation, reducing your system’s efficiency and risking costly repairs. If you experience ongoing issues despite troubleshooting, or if your system shows signs of corrosion or leaks, a professional can assess whether your resin needs replacement or if there’s a deeper problem. Don’t attempt complex repairs yourself if you’re unsure—specialists have the tools and expertise to diagnose issues accurately. Addressing these problems early can extend your system’s lifespan and ensure your water remains clean and safe.
Frequently Asked Questions
Can a Brine Tank Cause Water Taste Issues?
Yes, your brine tank can cause water taste issues. Salt buildup and mineral deposits in the tank can lead to unpleasant flavors, especially if the salt isn’t dissolved properly or if deposits clog the system. Regularly cleaning the tank and guaranteeing you use the right type of salt helps prevent these issues. Proper maintenance keeps mineral deposits at bay and ensures your water tastes fresh and clean.
How Often Should I Sanitize My Brine Tank?
You should sanitize your brine tank at least once a year to prevent bacteria buildup and maintain water quality. During brine tank cleaning, focus on thoroughly disinfecting the tank and ensuring proper salt level maintenance. Regularly check and refill the salt to avoid clumping or low levels, which can affect water taste. Keeping your brine tank clean and well-maintained helps ensure your water softener functions efficiently and produces great-tasting water.
What Are the Signs of Salt Contamination?
If you notice a strange taste or foul odor in your water, it’s a sign of salt contamination. You might also see cloudiness or salt bridges forming, indicating compromised salt purity. Additionally, tank corrosion can occur if contaminated salt isn’t addressed, risking damage to your system. Regularly check your brine tank, replace salt when needed, and clean to prevent salt contamination and protect your equipment’s longevity.
Does Water Temperature Affect Brine Tank Efficiency?
Water temperature does impact your brine tank’s efficiency, just like your water heater affects overall performance. When water is too hot, mineral buildup can occur more quickly, clogging the system and reducing salt effectiveness. Cold water, on the other hand, slows down the regeneration process. To keep your system running smoothly, maintain moderate water temperatures and regularly check for mineral buildup, ensuring ideal efficiency and longevity.
Can a Leaking Brine Tank Damage My Home?
A leaking brine tank can indeed damage your home, especially if the leak causes water to seep into leaking pipes or foundation cracks. Over time, continuous water exposure weakens structural elements, leading to costly repairs. If you notice any signs of a leak, like pooling water or damp spots near the tank, address it promptly to prevent further damage and protect your home’s integrity.
Conclusion
By busting myths, mastering maintenance, and monitoring your brine tank’s needs, you’ll keep your softener system smooth and secure. Stay vigilant about salt levels, spot signs of trouble early, and don’t hesitate to seek professional support when needed. With consistent care and a keen eye, you can prevent problems before they begin, ensuring your water stays soft, safe, and satisfying. Take charge, troubleshoot thoroughly, and enjoy the benefits of a beautifully balanced system.